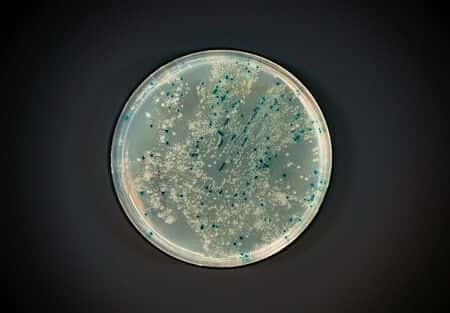
Pulmonology Experts Discuss Effects of Toxic Mold on Building Occupants

Pulmonology Experts Discuss Effects of Toxic Mold on Building Occupants
Updated on
Case Overview
This case involves a middle school teacher in Mississippi who began experiencing serious respiratory symptoms after a major flood occurred. After the flood, which had engulfed the first floor of the elementary school where she taught, had subsided, the school lacked sufficient funds to undertake repairs. The building structure had become irreparably damaged, and had become infested with termites and other pests . Instead, they opted to close off the damaged first floor of the building and hold classes on the second floor while the school district purchased modular classrooms. While teaching in the school, the teacher was diagnosed with asthma and bronchitis. She was treated with moxifloxacin hydrochloride. After a few months, she collapsed while teaching and was rushed to the hospital. It was alleged that the flooded conditions on the school’s first floor had led to the growth of toxic black mold throughout the school building.
Questions to the Internal Medicine expert and their responses
Do you have extensive experience treating patients who have who have suffered increased asthma and bronchitis due to poor air quality?
I have substantial expertise in, and experience with, poor air quality related diseases - over 25 years worth. I was on an EPA panel that reviewed one of the largest cases of asbestos contamination in history. In addition, I am the editor of a major textbook on occupational medicine, and I have written multiple chapters and reviews on occupational lung diseases. I have served on multiple advisory committees, and am a frequent participant in advisory activities due to my expertise in occupational lung diseases, including asbestos and sick building cases. I have served for 2 years as Chair of Environmental and Public Health Assembly at the American Thoracic Society, as well as serving as a board member of the same.
About the expert
This extremely qualified expert is board certified in internal, occupational and pulmonary medicine and has been practicing for 29+ years. She completed her internship and residency training at Yale University before concluding two fellowships focusing on occupational, environmental, pulmonary and critical care medicine at Yale University and at the University of Washington. She is a fellow at both the American College of Chest Physicians and the American College of Occupational and Environmental Medicine, and a member of various other professional organizations, including the American Thoracic Society. She has published 90+ peer-reviewed journal articles and serves as a reviewer for 5 renowned medical journals. She lectures both nationally and internationally and has been listed in New York Magazine's list of the best pulmonary doctors in New York for 12 consecutive years. Currently, she is the director of the occupational and environmental medicine program and of the preventive medicine residency program at a top 5 university, where she also works as a professor of pulmonary medicine. She is also the co-medical director of occupational health services at a major hospital and a staff physician at another major hospital in Connecticut.
E-011958
Specialties:
Subscribe to our newsletter
Join our newsletter to stay up to date on legal news, insights and product updates from Expert Institute.
Sign up nowFind an expert witness near you
What State is your case in?
Subscribe to our newsletter
Join our newsletter to stay up to date on legal news, insights and product updates from Expert Institute.